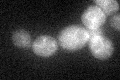
YNL066W
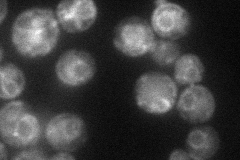
YNL066W

View description
Cell wall protein related to glucanases, possibly involved in cell wall septation; member of the SUN family
Localization:
Intensity:
Fold change:
Significance:
-
C’ GFP library in SD
vacuole membrane27.78 -
N' NOP1pr-GFP in SD
ER,punctate49.0474 -
N' TEF2pr-mCherry in SD

vacuole,bud neck13.24 -
N' NATIVEpr-GFP in SD

cytosol30.4315 -
N' TEF2pr-VC and Cyto-VN in SD

#N/A0 -
C’ GFP library in SD+DTT

vacuole membrane17.180.61Yes -
C’ GFP library in SD+H2O2

vacuole membrane26.340.94No -
C’ GFP library in Starvation Media

vacuole membrane18.190.65Yes -
C’ GFP library on the background of Pup2-DaMP

vacuole membrane -
C’ GFP library on the background of CCT mutant

vacuole membrane33.17481.19386No
